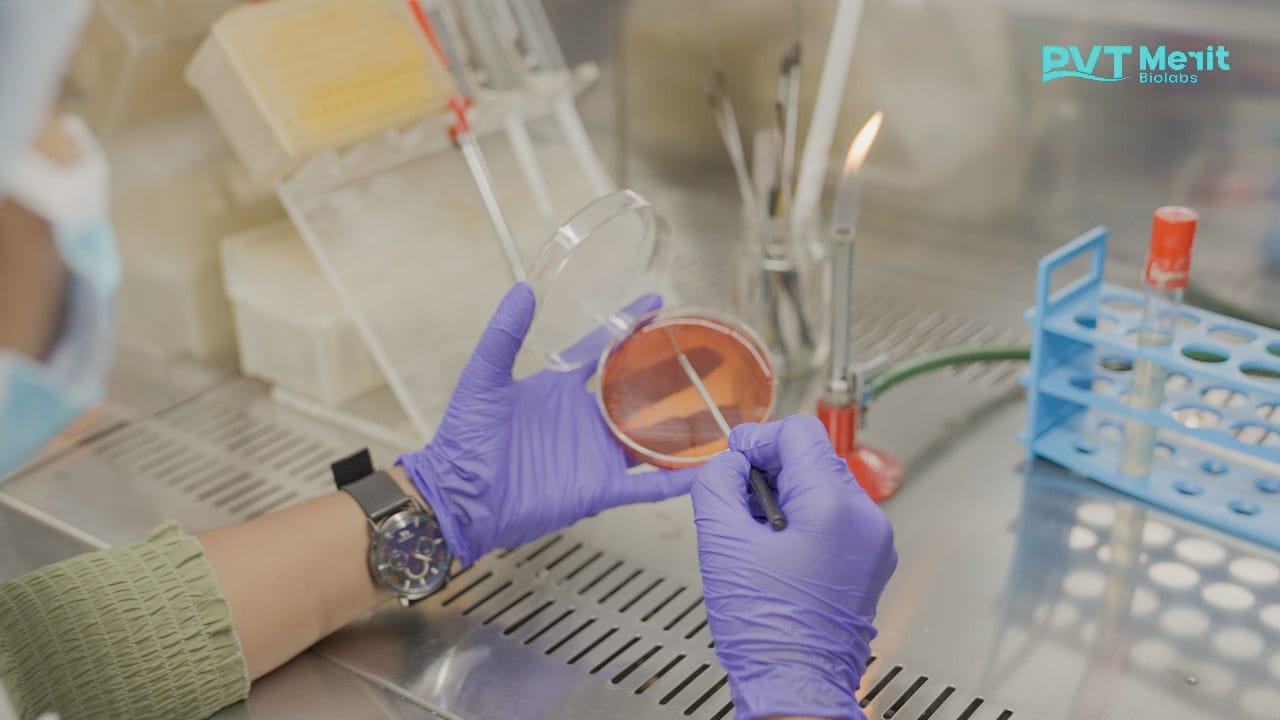

- [email protected]
- +91 83019 42889
Contact Us to schedule a consultation or to learn more about how our services can benefit your organization.
At Pvt Merit Bio Lab, we specialize in guiding businesses through the intricate landscape of certification, compliance, and process improvement. Our dedicated consulting services are designed to ensure that your operations meet the highest standards, enhance product quality, and achieve regulatory excellence.
Lorem ipsum dolor sit amet consectetur adipiscing.
Lorem ipsum dolor sit amet consectetur adipiscing.
Lorem ipsum dolor sit amet consectetur adipiscing.

Duis condimentum nunc metus, maximus porta velit temporin. Intincidunt leo viverra, sodales ex eu, posuere purus. Duis in augue vestibulum, aliquet nulla vitae, tempus tellus. Phasellus sit amet scelerisque quam, vitae vulputate massa. Sed tempus consequat nisi eu tristique scelerisque quam aliquet nulla.
Pellentesque et scelerisque nunc. Sed vel ipsum auctor, iaculis arcu quis, posuere dui. Duis condimentum nunc metus, maximus porta velit temporin. Intincidunt leo viverra, sodales ex eu, posuere purus. Duis in augue vestibulum, aliquet nulla vitae, tempus tellus. Phasellus sit amet scelerisque quam, vitae vulputate massa. Sed tempus consequat nisi eu tristique scelerisque quam aliquet nulla.
Duis condimentum nunc metus, maximus porta velit temporin.
Lorem ipsum dolor sit amet, consectetuer adipiscing elit. Aenean commodo ligula eget dolor. Aenean massaum sociis natoque penatibus.
Lorem ipsum dolor sit amet, consectetuer adipiscing elit. Aenean commodo ligula eget dolor. Aenean massaum sociis natoque penatibus.
Lorem ipsum dolor sit amet, consectetuer adipiscing elit. Aenean commodo ligula eget dolor. Aenean massaum sociis natoque penatibus.
WhatsApp us